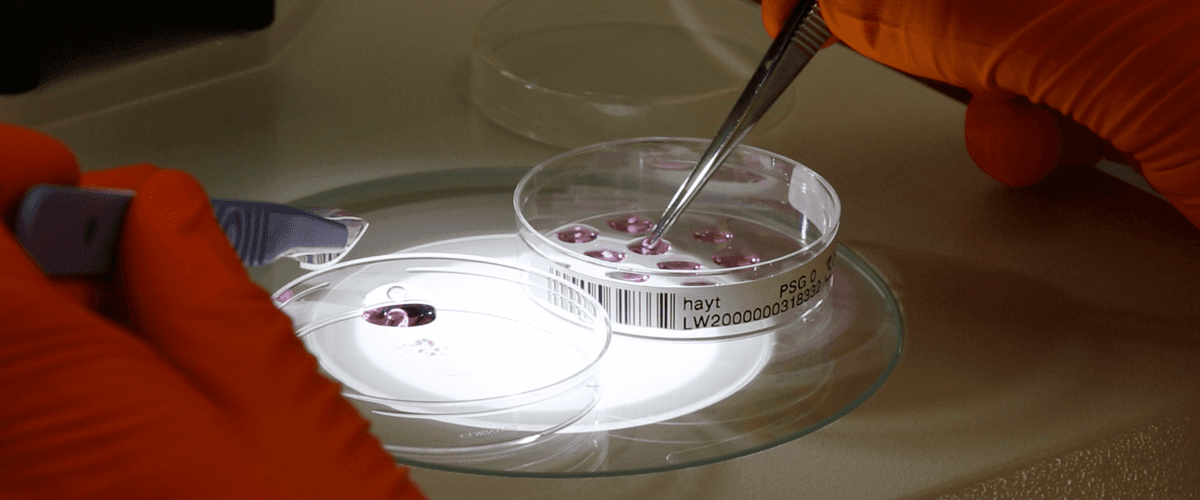
TODO:

Исследователи из Сенгеровского института (Великобритания) использовали технологию генного редактирования CRISPR, чтобы выявить гены, необходимые для выживания раковой опухоли. Проанализировав образцы 30 различных типов рака, они обнаружили около 600 таких генов.
Среди них — ген фермента ДНК-геликазы RecQ, который играет ключевую роль в развитии некоторых нестабильных опухолей, не поддающихся современным методам лечения.
Как отмечает Guardian, что точная карта генов-мишеней позволит разрабатывать лекарства против рака с большей эффективностью. В настоящее время разработка единственного нового антиракового препарата обходится более чем в $1 млрд, причем 90% проектов завершаются неудачей.
Кроме того, новый подход поможет избавить пациентов от методик, которые вызывают тяжелые побочные эффекты — таких, как химиотерапия и облучение.
Коллеги высоко оценили разработку команды. В первую очередь их впечатлил масштаб проделанного исследования. На следующем этапе планируется тщательно проанализировать каждый из генов-мишеней, выделив наиболее перспективные.
В США успешно испытали «вакцину» против лимфомы. Эксперимент с участием 11 человек подтвердил, что стимуляция иммунных клеток может полностью уничтожить опухоль и раковые клетки, распространившиеся по организму.